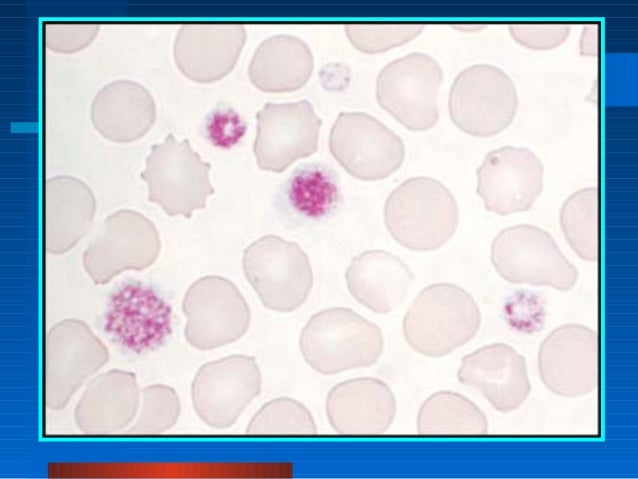

PLATELET DISORDERS PINPOINT RASH SKIN
Larger hemorrhages in the skin or mucous membranesĭecreased concentration of platelets in the peripheral bloodĪ congenital or acquired defect in plateletīinding of platelets to the vessel wall at the site of injury Small pinpoint hemorrhages in the skin or mucous membranes The sequential activation of these factors culminates in the end result of the formation of a fibrin clot from fibrinogenĪ general term for any abnormality of hemostasis including platelets, adhesive proteins, or soluble coagulation factorsįavoring or inducing the formation of a clotĪ defect related to abnormal concentration or function of one or more soluble coagulation factors Terminology associated with bleeding disordersĪ group of soluble coagulation proteins in the peripheral blood, referred to by Roman numerals (i.e., Factor VIII). Historical information that would suggest the presence of a bleeding disorder rather than bleeding due to local tissue factors would include a history or numerous prior bleeding episodes, a recognized breed predisposition to congenital hemostatic defects, and known exposure to a drug affecting hemostasis.

The presence of bleeding disorders can usually be confirmed by a combination of history, clinical signs, and screening tests of the hemostatic system. For example, epistaxis may result from bleeding disorders such as thrombocytopenia or nasal disease. Bleeding disorders must be differentiated from hemorrhage secondary to local tissue factors (i.e., trauma, neoplasia, inflammation). Using the problem-oriented approach described in Chapter 1, identify the most important problems and develop an initial plan for each with emphasis on the problems of petechiae and ecchymoses.īleeding disorders are conditions in which there is either spontaneous hemorrhage or excessive hemorrhage in response to tissue trauma secondary to one or more abnormalities in hemostasis (see Table 15-1 for definitions). Auscultation revealed a grade II/VI holosystolic murmur over the mitral valve area. The mucous membranes were pale and the capillary refill time was less than 3 seconds (normal).Īn enlarged spleen was present on abdominal palpation.

The dog was depressed and petechial and ecchymotic hemorrhages were present on the feet, neck, and abdomen. The temperature (102.4☏), heart rate (120 bpm), and respiratory rate (20 rpm) were normal. A cortisone injection was repeated and this time a swelling developed immediately at the injection site. The dog seemed to improve, but 1 month ago red skin splotches were once again noticed. According to the owner, about 4 months ago the skin rash had been treated by another veterinarian with a cortisone injection and cortisone tablets. A 3-year-old 6.5 kg female peekapoo is presented because the owner has seen blood in the stool, a “skin rash,” and red “splotches” in the skin.
